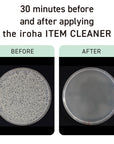
iroha ITEM CLEANER

iroha ITEM CLEANER
A loving cleanse for your iroha
In order to enjoy self-pleasure with peace of mind, it is important to take care of your iroha by properly cleaning them.
As something that comes in contact with your body, it should be made of ingredients that are gentle on the skin, and should be easy to use for daily care.
Apply with one push and wipe off with a tissue — Contains silver ions and mild ingredients to clean delicate items, plus it is mildly acidic so it can be freely used before or after a self-pleasure session.
Cleaning Effect — Keeps your iroha sanitary for peace of mind
* Test results based on the "Japanese Pharmacopoeia Reference Information: Evaluation Method of Disinfectants"
Designed to work perfectly with iroha products — Safe to use with silicone. Patch tested and allergy tested to be safe on the skin.
*Some individuals may experience skin irritations.
Compact and portable design — The portable size means it is always by your side. You can store it in your favorite pouch – have it always ready wherever you go!
No rinsing required — No need to get up and go the bathroom – just wipe off the foam with a tissue, so you can relax and enjoy your self-pleasure time even more.
Ingredients: Water, Butylene Glycol, Decyl Glucoside, Tea-Cocoyl Glutamate, Silver Oxide, o-Cymen-5-ol, Citric Acid, Sodium Citrate, Phenoxyethanol
US Orders - Ships within 1-3 business days
International Orders - Ships within 1-3 business days and up to 3 weeks for delivery, depending on location.